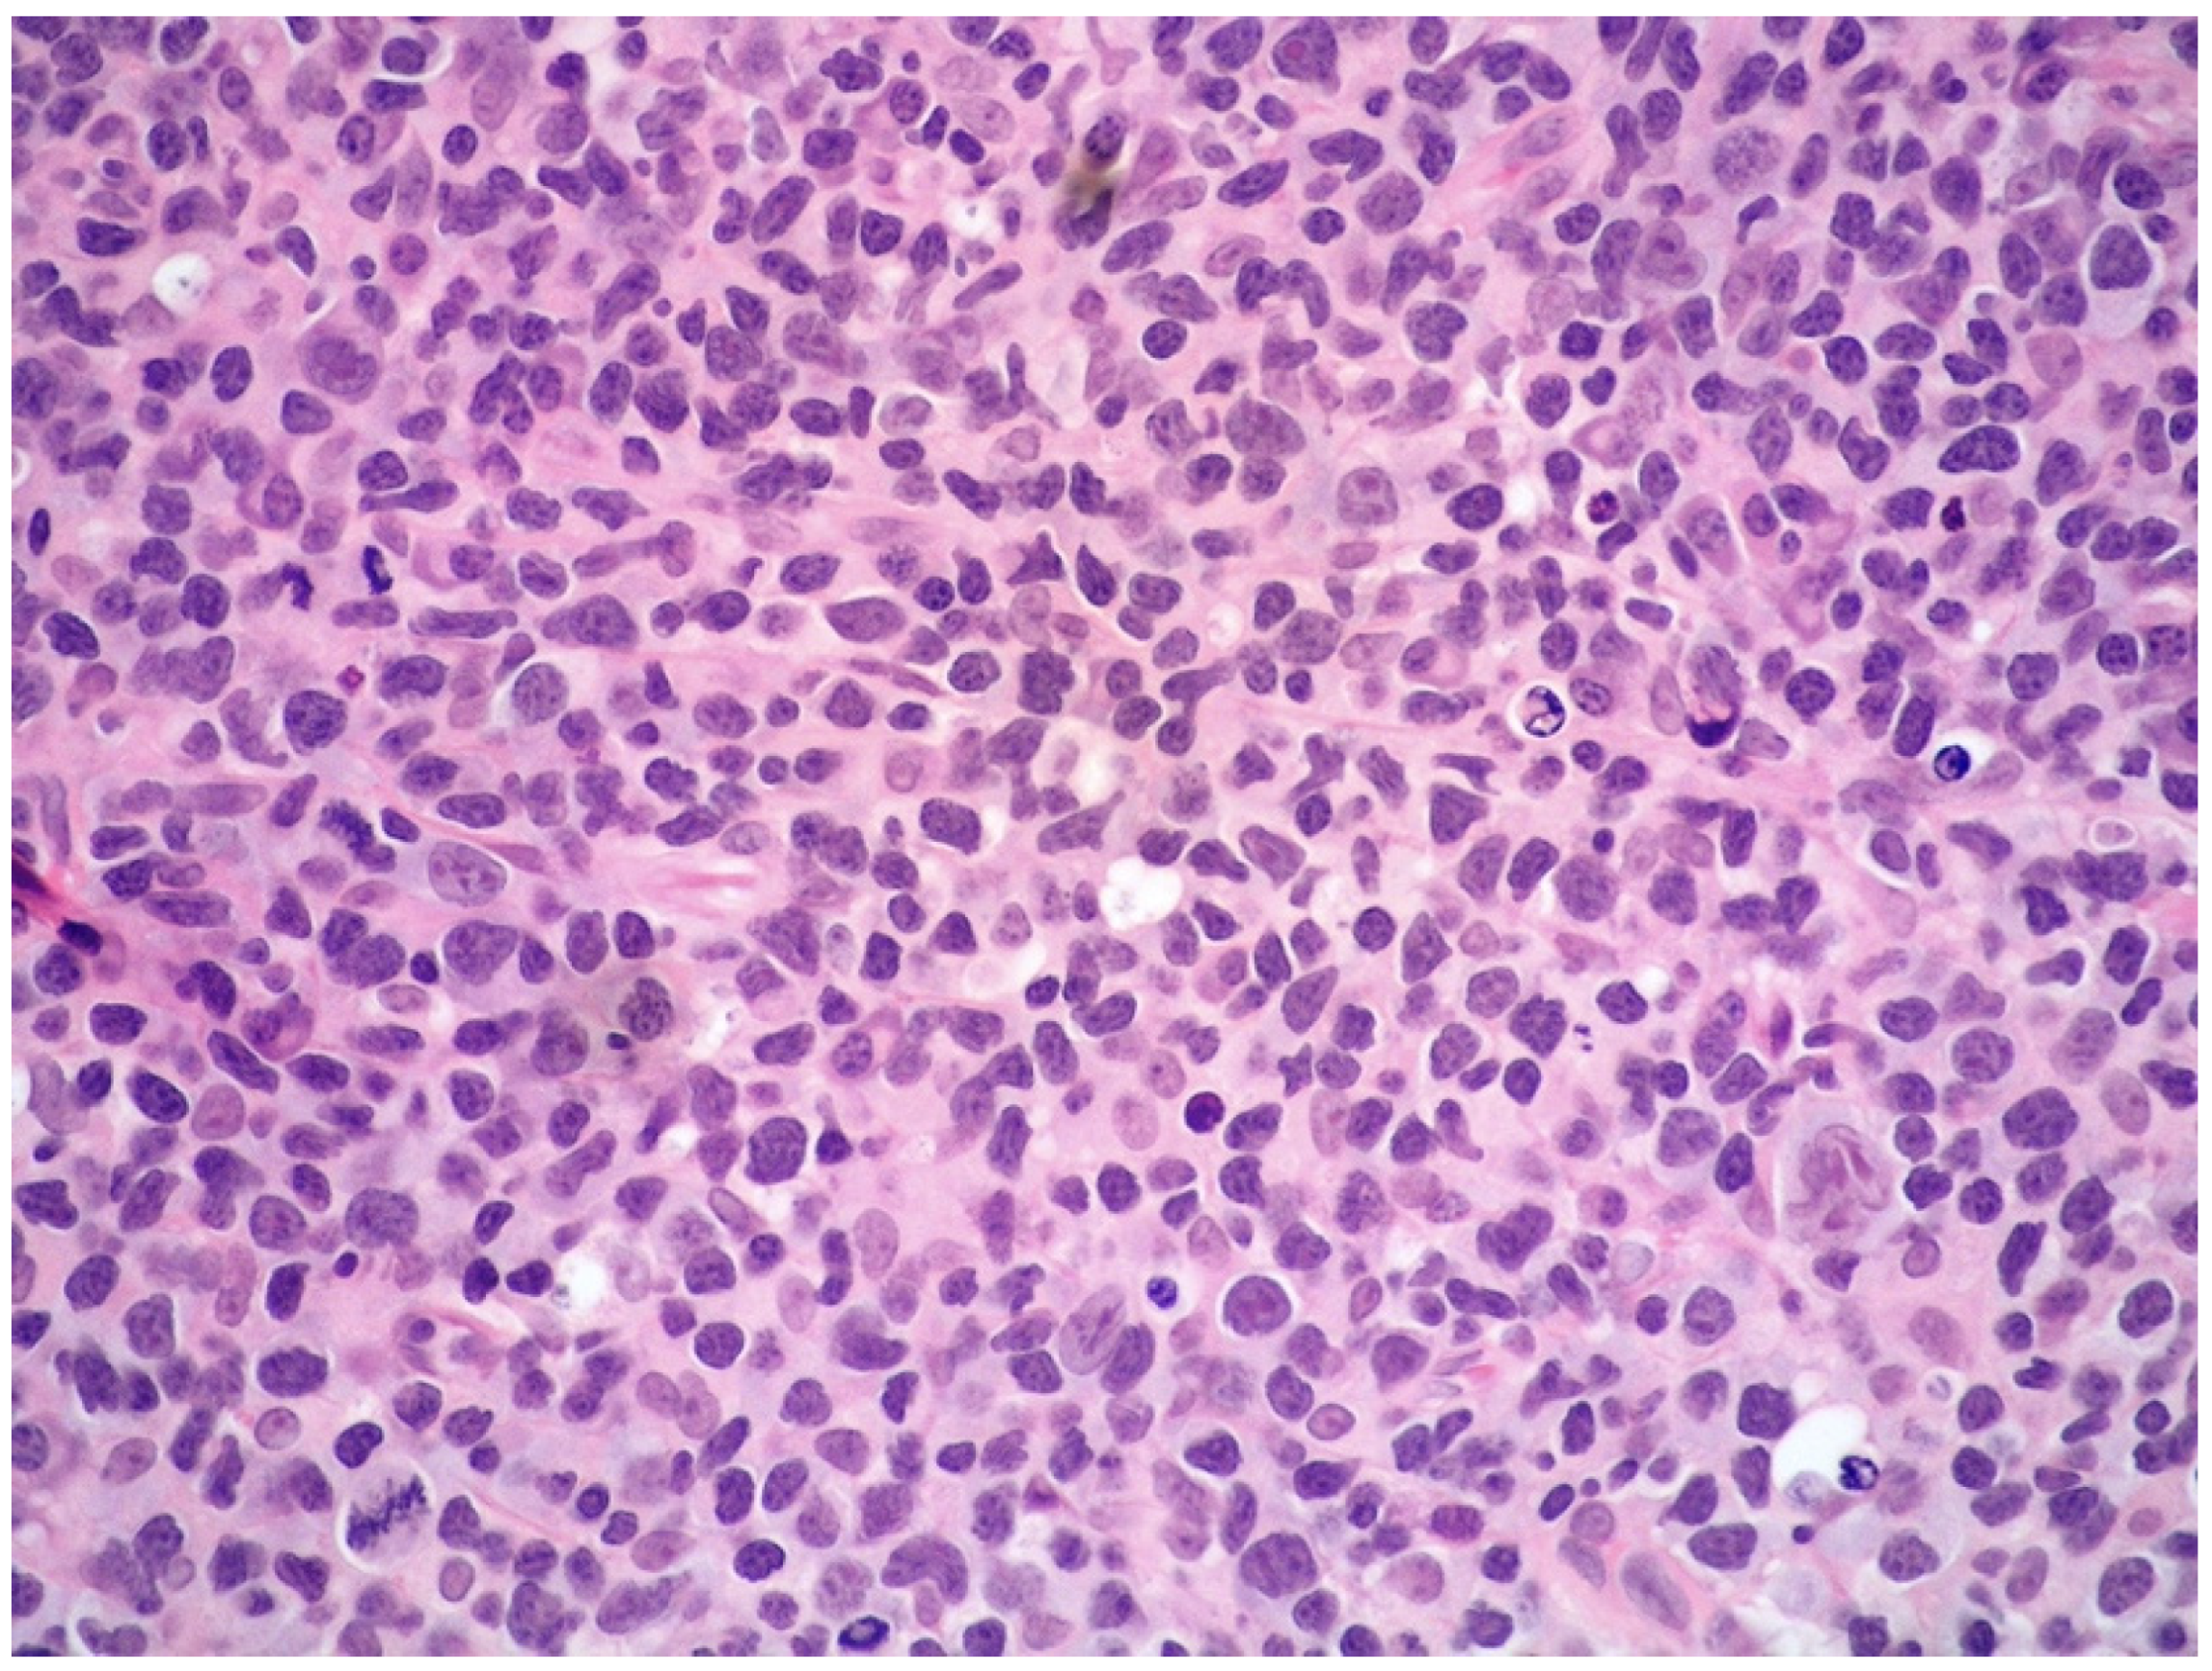

Intravascular NK/T-Cell Lymphoma: What We Know about This Diagnostically Challenging, Aggressive Disease
Abstract
Simple Summary
Abstract
1. Introduction
2. Overview on EBV Biology
3. Overview on the PD-1/PD-L1 Axis and Its Relation to EBV in Lymphomas
4. Clinicopathological Features of IVNKTL
5. Molecular Features and Pathogenesis of IVNKTL
6. Differential Diagnoses of IVNKTL
6.1. ENKTL, ANKL, and EBV-Positive Nodal T/NK Lymphoma
6.2. Extranodal NK/T-Cell Lymphoma (ENKTL)
6.2.1. General Features and Clinical Manifestations
6.2.2. Histology
6.2.3. Immunophenotypic Features
6.2.4. Genetic Features
6.2.5. Treatment
6.3. EBV-Positive Nodal T/NK-Cell Lymphoma
6.3.1. General Features and Clinical Manifestations
6.3.2. Histology and Immunophenotypic Features
6.3.3. Genetic Features
6.4. Aggressive NK-Cell Leukemia (ANKL)
6.4.1. General Features and Clinical Manifestations
6.4.2. Histology and Immunophenotypic Features
6.4.3. Genetic Features
6.4.4. Treatment
7. Conclusions
Author Contributions
Funding
Acknowledgments
Conflicts of Interest
References
- Santucci, M.; Pimpinelli, N.; Massi, D.; Kadin, M.E.; Meijer, C.J.L.M.; Muller-Hermelink, H.K.; Paulli, M.; Wechsler, J.; Willemze, R.; Audrig, H.; et al. EORTC cutaneous Lymphoma Task Force. Cytotoxic/natural killer cell cutaneous lymphomas. Report of EORTC cutaneous lymphoma Task Force workshop. Cancer 2003, 97, 610–627. [Google Scholar] [CrossRef] [PubMed]
- Wu, H.; Said, J.W.; Ames, E.D.; Chen, C.; McWorther, V.; Chen, P.; Ghali, V.; Pinkus, G.S. First reported cases of intravascular Large cell lymphoma of the NK cell type. Am. J. Clin. Pathol. 2005, 123, 603–611. [Google Scholar] [CrossRef] [PubMed]
- Kuo, T.-T.; Chen, M.-J.; Kuo, M.-C. Cutaneous intravascular NK-cell lymphoma: Report of a rare variant associated with Ep-stein-Barr virus. Am. J. Surg. Pathol. 2006, 30, 1197–1201. [Google Scholar] [CrossRef]
- Song, D.E.; Lee, M.-W.; Ryu, M.-H.; Kang, D.W.; Kim, S.J.; Huh, J. Intravascular Large Cell Lymphoma of the Natural Killer Cell Type. J. Clin. Oncol. 2007, 25, 1279–1282. [Google Scholar] [CrossRef] [PubMed]
- Nakamichi, N.; Fukuhara, S.; Aozasa, K.; Morii, E. NK-cell intravascular lymphomatosis—A mini-review. Eur. J. Haematol. 2008, 81, 1–7. [Google Scholar] [CrossRef] [PubMed]
- Gleason, B.C.; Brinster, N.K.; Granter, S.R.; Pinkus, G.S.; Lindeman, N.I.; Miller, D.M. Intravascular cytotoxic T-cell lymphoma: A case report and review of the literature. J. Am. Acad. Dermatol. 2008, 58, 290–294. [Google Scholar] [CrossRef]
- Cerroni, L.; Massoni, C.; Kutzner, H.; Mentzel, T.; Umbert, P.; Kerl, H. Intravascular large T-cell or NK-cell lymphoma: A rare variant of intravascular large cell lymphoma with frequent cytotoxic phenotype and association with Epstein-Barr virus infection. Am. J. Surg. Pathol. 2008, 32, 891–898. [Google Scholar] [CrossRef]
- Wu, C.; Liao, J.; Hsieh, P.; Hwang, Y.; Lin, S. Cutaneous Intravascular Natural Killer-cell Lymphoma: A Rare Case and Review of the Literature. Acta Derm. Venereol. 2011, 91, 472–473. [Google Scholar] [CrossRef]
- Yanning, X.; Chen, H.; Si, H.; Liu, Y.; Min, Z. Cutaneous intravascular NK-cell lymphoma. Eur. J. Dermatol. 2013, 23, 252–253. [Google Scholar] [CrossRef]
- Liu, Y.; Zhang, W.; An, J.; Li, H.; Liu, S. Cutaneous Intravascular Natural Killer–Cell Lymphoma. Am. J. Clin. Pathol. 2014, 142, 243–247. [Google Scholar] [CrossRef]
- Bi, Y.; Huo, Z.; Liang, Z.; Yunxiao, M.Y.; Jia, C.; Shi, X.; Song, L.; Luo, Y.; Ling, Q.; Liu, T. Intravascular NK-cell lymphoma: A case report and review of the literature. Diagn. Pathol. 2015, 10, 84. [Google Scholar] [CrossRef] [PubMed]
- Wang, L.; Chen, S.; Ma, H.; Shi, D.; Huang, C.; Lu, C.; Gao, T.; Wang, G. Intravascular NK/T-cell lymphoma: A report of five cases with cutaneous manifestation from China. J. Cutan. Pathol. 2015, 42, 610–617. [Google Scholar] [CrossRef] [PubMed]
- Sharma, T.L.; Yeaney, G.A.; Soltanzadeh, P.; Li, Y.; Cotta, C.V. Intravascular T-cell lymphoma: A rare, poorly characterized entity with cytotoxic phenotype. Neuropathology 2017, 37, 365–370. [Google Scholar] [CrossRef]
- Yan, J.; Zhang, F.; Luo, D.; Yao, S.; Chen, Y.; Xu, F.; Luo, X.; He, J.; Liu, Y. Intravascular NK/T-cell lymphoma: A series of four cases. Int. J. Clin. Exp. Pathol. 2017, 10, 9541–9550. [Google Scholar] [PubMed]
- Alegría-Landa, V.; Manzarbeitia, F.; Calderón, M.G.S.; Requena, L.; Rodríguez-Pinilla, S.M. Cutaneous intravascular natural killer/T cell lymphoma with peculiar immunophenotype. Histopathology 2017, 71, 994–1002. [Google Scholar] [CrossRef] [PubMed]
- Okonkwo, L.; Jaffe, E.S. Intravascular large cell lymphoma of NK/T-cell type, EBV positive. Blood 2017, 130, 837. [Google Scholar] [CrossRef]
- Elshiekh, M.; Naresh, K.N. A rare case of renal intravascular NK/T-cell lymphoma. Blood 2018, 132, 1354. [Google Scholar] [CrossRef]
- Zanelli, M.; Mengoli, M.C.; Del Sordo, R.; Cagini, A.; De Marco, L.; Simonetti, E.; Martino, G.; Zizzo, M.; Ascani, S. Intravascular NT/T-cell lymphoma, Epstein-Barr virus positive with multiorgan involvement: A clinical dilemma. BMC Cancer 2018, 18, 1115. [Google Scholar] [CrossRef]
- Fujikura, K.; Yamashita, D.; Sakamoto, R.; Ishikawa, T.; Chuang, S.-S.; Itoh, T.; Imai, Y. Intravascular NK/T-cell lymphoma: Clinicopathological and integrated molecular analysis of two cases provides a clue to disease pathogenesis. J. Clin. Pathol. 2019, 72, 642–646. [Google Scholar] [CrossRef]
- Wang, J.; Yang, X.; Song, Z.; You, Y. Cutaneous intravascular NK/T-cell lymphoma. Australas. J. Dermatol. 2019, 61, 61–63. [Google Scholar] [CrossRef]
- Fujikura, K.; Yoshida, M.; Uesaka, K. Transcriptome complexity in intravascular NK/T-cell lymphoma. J. Clin. Pathol. 2020, 73, 671–675. [Google Scholar] [CrossRef] [PubMed]
- WHO Classification of Tumours Editorial Board (Ed.) WHO Classification of Tumours Haematopoietic and Lymphoid Tissues, Revised 4th ed.; IARC: Lyon, France, 2017. [Google Scholar]
- Sánchez-Romero, C.; Bologna-Molina, R.; de Almeida, O.P.; Santos-Silva, A.R.; Prado-Ribeiro, A.C.; Brandão, T.B.; Carlos, R. Extranodal NK/T cell lymphoma, nasal type: An updated overview. Crit. Rev. Oncol. 2021, 159, 103237. [Google Scholar] [CrossRef] [PubMed]
- Huang, Y.; de Leval, L.; Gaulard, P. Molecular underpinning of extranodal NK/T-cell lymphoma. Best Pr. Res. Clin. Haematol. 2013, 26, 57–74. [Google Scholar] [CrossRef] [PubMed]
- Takata, K.; Hong, M.E.; Sitthinamsuwan, P.; Loong, F.; Tan, S.Y.; Liau, J.Y.; Hsieh, P.P.; Ng, S.B.; Yang, S.F.; Pongpruttipan, T.; et al. Primary cutaneous NK/T-cell lymphoma, nasal type and CD56-positive peripheral T-cell lymphoma: A cellular lineage and clinicopathologic study of 60 patients from Asia. Am. J. Surg. Pathol. 2015, 39, 1–12. [Google Scholar] [CrossRef]
- Syrykh, C.; Péricart, S.; Lamaison, C.; Escudié, F.; Brousset, P.; Laurent, C. Epstein–Barr Virus-Associated T- and NK-Cell Lymphoproliferative Diseases: A Review of Clinical and Pathological Features. Cancers 2021, 13, 3315. [Google Scholar] [CrossRef] [PubMed]
- Takada, H.; Imadome, K.I.; Shibayama, H.; Yoshimori, M.; Wang, L.; Saitoh, Y.; Uota, S.; Yamaoka, S.; Koyama, T.; Shimizu, N.; et al. EBV induces persistent NF-kB activation and contributes to survival of EBV-positive neoplastic T-or NK-cells. PLoS ONE 2017, 12, e0174136. [Google Scholar]
- Zanelli, M.; Sanguedolce, F.; Palicelli, A.; Zizzo, M.; Martino, G.; Caprera, C.; Fragliasso, V.; Soriano, A.; Gozzi, F.; Cimino, L.; et al. EBV-Driven Lymphoproliferative Disorders and Lymphomas of the Gastrointestinal Tract: A Spectrum of Entities with a Common Denominator (Part 3). Cancers 2021, 13, 6021. [Google Scholar] [CrossRef]
- Alaggio, R.; Amador, C.; Anagnostopoulos, I.; Ayoma, D.; Attygalle, A.D.; de Oliveira Araujo, I.B.; Borges, A.M.; Boyer, D.; Calaminici, M.; Chadburn, A.; et al. The 5th edition of the World Health Organization Classification of Haematolymphoid Tumours: Lymphoid Neoplasms. Leukemia 2022, 36, 1720–1748. [Google Scholar] [CrossRef]
- Taylor, G.S.; Long, H.M.; Brooks, J.M.; Rickinson, A.B.; Hislop, A.D. The Immunology of Epstein-Barr Virus–Induced Disease. Annu. Rev. Immunol. 2015, 33, 787–821. [Google Scholar] [CrossRef]
- Young, L.; Yap, L.-F.; Murray, P.G. Epstein–Barr virus: More than 50 years old and still providing surprises. Nat. Cancer 2016, 16, 789–802. [Google Scholar] [CrossRef]
- Rickinson, A. Co-infections, inflammation and oncogenesis: Future directions for EBV research. Semin. Cancer Biol. 2014, 26, 99–115. [Google Scholar] [CrossRef] [PubMed]
- Price, A.M.; Luftig, M.A. To Be or Not IIb: A Multi-Step Process for Epstein-Barr Virus Latency Establishment and Consequences for B Cell Tumorigenesis. PLOS Pathog. 2015, 11, e1004656. [Google Scholar] [CrossRef] [PubMed]
- Dojcinov, S.; Fend, F.; Quintanilla-Martinez, L. EBV-Positive Lymphoproliferations of B- T- and NK-Cell Derivation in Non-Immunocompromised Hosts. Pathogens 2018, 7, 28. [Google Scholar] [CrossRef]
- Fujiwara, S.; Kimura, H. Editorial: Epstein-Barr Virus-Associated T/NK-Cell Lymphoproliferative Diseases. Front. Pediatr. 2019, 7, 285. [Google Scholar] [CrossRef] [PubMed]
- Kim, W.Y.; Montes-Mojarro, I.A.; Fend, F.; Quintanilla-Martinez, L. Epstein-Barr virus-associated T and NK-cell lymphopro-liferative diseases. Front. Pediatr. 2019, 7, 71. [Google Scholar] [CrossRef] [PubMed]
- Kimura, H.; Fujiwara, S. Overview of EBV-Associated T/NK-Cell Lymphoproliferative Diseases. Front. Pediatr. 2019, 6, 417. [Google Scholar] [CrossRef]
- Kim, H.; Ko, Y.H. The Pathologic and Genetic Characteristics of Extranodal NK/T-Cell Lymphoma. Life 2022, 12, 73. [Google Scholar] [CrossRef] [PubMed]
- Zanelli, M.; Sanguedolce, F.; Palicelli, A.; Zizzo, M.; Martino, G.; Caprera, C.; Fragliasso, V.; Soriano, A.; Valle, L.; Ricci, S.; et al. EBV-driven lymphoproliferative disorders and lymphomas of the gastrointestinal tract: A spectrum of entities with a common denominator (Part 1). Cancers 2021, 13, 4578. [Google Scholar] [CrossRef]
- Zanelli, M.; Sanguedolce, F.; Palicelli, A.; Zizzo, M.; Martino, G.; Caprera, C.; Fragliasso, V.; Soriano, A.; Valle, L.; Ricci, S.; et al. EBV-driven lymphoproliferative disorders and lymphomas of the gastrointestinal tract: A spectrum of entities with a common denominator (Part 2). Cancers 2021, 13, 4527. [Google Scholar] [CrossRef]
- Patsoukis, N.; Wang, Q.; Strauss, L.; Boussiotis, V.A. Revisiting the PD-1 pathway. Sci. Adv. 2020, 6, eabd2712. [Google Scholar] [CrossRef]
- Lipson, E.J.; Forde, P.M.; Hammers, H.-J.; Emens, L.A.; Taube, J.M.; Topalian, S.L. Antagonists of PD-1 and PD-L1 in Cancer Treatment. Semin. Oncol. 2015, 42, 587–600. [Google Scholar] [CrossRef]
- Alsaab, H.O.; Sau, S.; Alzhrani, R.; Tatiparti, K.; Bhise, K.; Kashaw, S.K.; Iyer, A.K. PD-1 and PD-L1 chechpoint signaling inhibition for cancer immunotherapy: Mechanism, combinations and clinical outcome. Front. Pharmacol. 2017, 8, 561. [Google Scholar] [CrossRef] [PubMed]
- Palicelli, A.; Bonacini, M.; Croci, S.; Magi-Galluzzi, C.; Cañete-Portillo, S.; Chaux, A.; Bisagni, A.; Zanetti, E.; De Biase, D.; Melli, B.; et al. What Do We Have to Know about PD-L1 Expression in Prostate Cancer? A Systematic Literature Review. Part 1: Focus on Immunohistochemical Results with Discussion of Pre-Analytical and Interpretation Variables. Cells 2021, 10, 3166. [Google Scholar] [CrossRef]
- Ansell, S.M.; Lesokhin, A.M.; Borrello, I.; Halwani, A.; Scott, E.C.; Gutierrez, M.; Schuster, S.J.; Millenson, M.M.; Cattry, D.; Freeman, G.J.; et al. PD-1 Blockade with Nivolumab in Relapsed or Refractory Hodgkin’s Lymphoma. N. Engl. J. Med. 2015, 372, 311–319. [Google Scholar] [CrossRef] [PubMed]
- Lesokhin, A.M.; Ansell, S.M.; Armand, P.; Scott, E.C.; Halwani, A.; Gutierrez, M.; Millenson, M.M.; Cohen, A.D.; Schuster, S.J.; Lebovic, D.; et al. Nivolumab in patients with repalsed or refractory hematologic malignancy: Preliminary results of a phase Ib study. J. Clin. Oncol. 2016, 34, 2698–2704. [Google Scholar] [CrossRef] [PubMed]
- Satou, A.; Nakamura, S. EBV-positive B-cell lymphomas and lymphoproliferative disorders: Review from the perspective of immune escape and immunodeficiency. Cancer Med. 2021, 10, 6777–6785. [Google Scholar] [CrossRef]
- Ferreri, A.J.; Dognini, G.P.; Campo, E.; Willemze, R.; Seymour, J.F.; Bairey, O.; Martelli, M.; De Renz, A.O.; Doglioni, C.; Montalban, C.; et al. Variations in clinical presentation, frequency of hemophagocytosis and clinical behavior of in-travascular lymphoma diagnosed in different geographical regions. Haematologica 2007, 92, 486–492. [Google Scholar] [CrossRef]
- Pastor, W.A.; Aravind, L.; Rao, A. TETonic shift: Biological roles of TET proteins in DNA demethylation and transcription. Nat. Rev. Mol. Cell Biol. 2013, 14, 341–356. [Google Scholar] [CrossRef]
- Bi, X.-W.; Wang, H.; Zhang, W.-W.; Wang, J.-H.; Liu, W.-J.; Xia, Z.-J.; Huang, H.-Q.; Jiang, W.-Q.; Zhang, Y.-J.; Wang, L. PD-L1 is upregulated by EBV-driven LMP1 through NF-κB pathway and correlates with poor prognosis in natural killer/T-cell lym-phoma. J. Hematol. Oncol. 2016, 9, 3432–3433. [Google Scholar] [CrossRef]
- Scheel, A.H.; Baenfer, G.; Baretton, G.; Dietel, M.; Diezko, R.; Henkel, T.; Heukamp, L.C.; Jasani, B.; Johrens, K.; Kirchner, T.; et al. Interlaboratory concordance of PD- L1 immunohistochemistry for non-small-cell lung cancer. Histopathology 2018, 72, 449–459. [Google Scholar] [CrossRef]
- Batenchuk, C.; Albitar, M.; Zerba, K.; Sudarsanam, S.; Chizhevsky, V.; Jin, C.; Burns, V. A real-world, comparative study of FDA-approved diagnostic assays PD-L1 IHC 28-8 and 22C3 in lung cancer and other malignancies. J. Clin. Pathol. 2018, 71, 1078–1083. [Google Scholar] [CrossRef] [PubMed]
- Menguy, S.; Prochazkova-Carlotti, M.; Beylot-Barry, M.; Saltel, F.; Vergier, B.; Merlio, J.-P.; Pham-Ledard, A. PD-L1 and PD-L2 Are Differentially Expressed by Macrophages or Tumor Cells in Primary Cutaneous Diffuse Large B-Cell Lymphoma, Leg Type. Am. J. Surg. Pathol. 2018, 42, 326–334. [Google Scholar] [CrossRef] [PubMed]
- Mitteldorf, C.; Berisha, A.; Pfaltz, M.C.; Broekaert, S.M.; Schön, M.P.; Kerl, K.; Kempf, W. Tumor Microenvironment and Checkpoint Molecules in Primary Cutaneous Diffuse Large B-Cell Lymphoma—New Therapeutic Targets. Am. J. Surg. Pathol. 2017, 41, 998–1004. [Google Scholar] [CrossRef]
- Sakakibara, A.; Kohno, K.; E Eladl, A.; Klaisuwan, T.; Ishikawa, E.; Suzuki, Y.; Shimada, S.; Nakaguro, M.; Shimoyama, Y.; Takahara, T.; et al. Immunohistochemical assessment of the diagnostic utility of PD-L1: A preliminary analysis of anti-PD-L1 antibody (SP142) for lymphoproliferative diseases with tumour and non-malignant Hodgkin-Reed-Sternberg (HRS)-like cells. Histopathology 2018, 72, 1156–1163. [Google Scholar] [CrossRef]
- Harrow, J.; Frankish, A.; Gonzalez, J.M.; Tapanari, E.; Diekhans, M.; Kokocinski, F.; Aken, B.L.; Barrell, D.; Zadissa, A.; Searle, S.; et al. GENCODE: The reference human genome annotation for The ENCODE Project. Genome Res. 2012, 22, 1760–1774. [Google Scholar] [CrossRef]
- Lee, Y.; Rio, D.C. Mechanisms and regulation of alternative pre-mRNA splicing. Annu. Rev. Biochem. 2015, 84, 291–323. [Google Scholar] [CrossRef] [PubMed]
- Venables, J.P. Aberrant and Alternative Splicing in Cancer. Cancer Res. 2004, 64, 7647–7654. [Google Scholar] [CrossRef]
- Anczuków, O.; Krainer, A.R. Splicing-factor alterations in cancers. RNA 2016, 22, 1285–1301. [Google Scholar] [CrossRef]
- Clemente-González, H.; Porta-Pardo, E.; Godzik, A.; Eyra, E. The functional impact of alternative splicing in cancer. Cell. Rep. 2017, 20, 2215–2226. [Google Scholar] [CrossRef]
- Koedoot, E.; Smid, M.; Foekens, J.A.; Martens, J.W.M.; Le Dévédec, S.E.; Van De Water, B. Co-regulated gene expression of splicing factors as drivers of cancer progression. Sci. Rep. 2019, 9, 5484. [Google Scholar] [CrossRef]
- Escobar-Hoyos, L.; Knorr, K.; Abdel-Wahab, O. Aberrant RNA Splicing in Cancer. Annu. Rev. Cancer Biol. 2019, 3, 167–185. [Google Scholar] [CrossRef] [PubMed]
- Rodrigues-Peres, R.M.; de S Carvalho, B.; Anurag, M.; Lei, J.T.; Conz, L.; Goncalves, R.; Filho, C.C.; Ramalho, S.; de Paiva, G.R.; Derchain, S.F.M.; et al. Copy number alterations associated with clinical features in an underrepresented population with breast cancer. Mol. Genet. Genomic.Med. 2019, 7, e00750. [Google Scholar] [CrossRef] [PubMed]
- Foy, A.; McMullin, M.F. Somatic SF3B1 mutations in myelodysplastic syndrome with ring sideroblasts and chronic lympho-cytic leukaemia. J. Clin. Pathol. 2019, 72, 778–782. [Google Scholar] [CrossRef] [PubMed]
- Kim, T.M.; Lee, S.Y.; Jeon, Y.K.; Ryoo, B.Y.; Cho, G.J.; Hong, Y.S.; Kim, H.J.; Kim, S.Y.; Kim, C.S.; Kim, S.; et al. Lymphoma Subcommittee of the Korean Cancer Study Group. Clinical heterogeneity of extranodal NK/T-cell lymphoma, nasal type: A national survey of the Korean Cancer Study Group. Ann. Oncol. 2008, 19, 1477–1484. [Google Scholar] [CrossRef]
- Au, W.-Y.; Weisenburger, D.D.; Intragumtornchai, T.; Nakamura, S.; Kim, W.-S.; Sng, I.; Vose, J.; Armitage, J.O.; Liang, R. Clinical differences between nasal and extranasal natural killer/T-cell lymphoma: A study of 136 cases from the International Peripheral T-Cell Lymphoma Project. Blood 2009, 113, 3931–3937. [Google Scholar] [CrossRef]
- Li, N.; Jiang, M.; Wu, W.-C.; Wei, W.-W.; Zou, L.-Q. How to Identify Patients at High Risk of Developing Nasal-Type, Extranodal Nature Killer/T-Cell Lymphoma-Associated Hemophagocytic Syndrome. Front. Oncol. 2021, 11, 704962. [Google Scholar] [CrossRef]
- Ling, Y.-H.; Zhu, C.-M.; Wen, S.-H.; Luo, R.-Z.; Li, P.; Cao, Y.; Rao, H.-L.; Lin, S.-X.; Cai, M.-Y. Pseudoepitheliomatous hyperplasia mimicking invasive squamous cell carcinoma in extranodal natural killer/T-cell lymphoma: A report of 34 cases. Histopathology 2015, 67, 404–409. [Google Scholar] [CrossRef]
- Pongpruttipan, T.; Sukpanichnant, S.; Assanasen, T.; Wannakrairot, P.; Boonsakan, P.; Kanoksil, W.; Kayasut, K.; Mitarnun, W.; Khuhapinant, A.; Bunworasate, U.; et al. Extranodal NK/T-cell lymphoma, nasal type, includes cases of natural killer cell and αβ, γδ, and αβ/γδ T-cell origin: A comprehensive clinicopathologic and phenotypic study. Am. J. Surg. Pathol. 2012, 6, 481–499. [Google Scholar] [CrossRef]
- Huang, Y.; Chen, S.; Wei, R.; Guo, X.; Yang, X.; Cao, Q.; Yang, Y.; Yun, J. CD20-positive extranodal NK/T cell lymphoma: Clinicopathologic and prognostic features. Virchows Arch. 2020, 477, 873–883. [Google Scholar] [CrossRef]
- Jo, J.-C.; Kim, M.; Choi, Y.; Kim, H.-J.; Kim, J.E.; Chae, S.W.; Kim, H.; Cha, H.J. Expression of programmed cell death 1 and programmed cell death ligand 1 in extranodal NK/T-cell lymphoma, nasal type. Ann. Hematol. 2016, 96, 25–31. [Google Scholar] [CrossRef]
- Tse, E.; Kwong, Y.-L. Recent Advances in the Diagnosis and Treatment of Natural Killer Cell Malignancies. Cancers 2022, 14, 597. [Google Scholar] [CrossRef]
- Xiong, J.; Zhao, W.-L. Advances in multiple omics of natural-killer/T cell lymphoma. J. Hematol. Oncol. 2018, 11, 134. [Google Scholar] [CrossRef]
- Coppo, P.; Gouilleux-Gruart, V.; Huang, Y.; Bouhlal, H.; Bouamar, H.; Bouchet, S.; Perrot, C.; Vieillard, V.; Dartigues, P.; Gaulard, P.; et al. STAT3 transcription factor is constitutively activated and is oncogenic in nasal-type NK/T-cell lymphoma. Leukemia 2009, 23, 1667–1678. [Google Scholar] [CrossRef] [PubMed]
- Huang, Y.; De Reyniès, A.; de Leval, L.; Ghazi, B.; Martin-Garcia, N.; Travert, M.; Bosq, J.; Brière, J.; Petit, B.; Thomas, E.; et al. Gene expression profiling identifies emerging oncogenic pathways operating in extranodal NK/T-cell lymphoma, nasal type. Blood 2010, 115, 1226–1237. [Google Scholar] [CrossRef] [PubMed]
- Nairismägi, M.; Gerritsen, M.E.; Li, Z.M.; Wijaya, G.C.; Chia, B.K.H.; Laurensia, Y.; Lim, J.Q.; Yeoh, K.W.; Yao, X.S.; Pang, W.L.; et al. Oncogenic activation of JAK3-STAT signaling confers clinical sensitivity to PRN371, a novel selective and potent JAK3 inhibitor, in natural killer/T-cell lymphoma. Leukemia 2018, 32, 1147–1156. [Google Scholar] [CrossRef] [PubMed]
- Dong, G.; Li, Y.; Lee, L.; Liu, X.; Shi, Y.; Liu, X.; Bouska, A.; Gong, Q.; Kong, L.; Wang, J.; et al. Genetic manipulation of primary human natural killer cells to investigate the functional and oncogenic roles of PRDM1. Haematologica 2020, 106, 2427–2438. [Google Scholar] [CrossRef]
- Kwong, Y.L.; Kim, W.S.; Lim, S.T.; Kim, S.J.; Tang, T.; Tse, E.; Leung, A.Y.; Chim, C.S. SMILE for natural killer/T-cell lymphoma: Analysis of safety and efficacy from the Asia Lymphoma Study Group. Blood 2012, 120, 2973–2980. [Google Scholar] [CrossRef]
- Sun, K.-H.; Wong, Y.-T.; Cheung, K.-M.; Yuen, C.; Chan, Y.-T.; Lai, W.-Y.; Chao, C.; Fan, W.-S.; Chow, Y.-K.; Law, M.-F.; et al. Update on Molecular Diagnosis in Extranodal NK/T-Cell Lymphoma and Its Role in the Era of Personalized Medicine. Diagnostics 2022, 12, 409. [Google Scholar] [CrossRef]
- Tse, E.; Zhao, W.-L.; Xiong, J.; Kwong, Y.-L. How we treat NK/T-cell lymphomas. J. Hematol. Oncol. 2022, 15, 74. [Google Scholar] [CrossRef]
- Kwong, Y.-L.; Chan, T.S.Y.; Tan, D.; Kim, S.J.; Poon, L.-M.; Mow, B.; Khong, P.-L.; Loong, F.; Au-Yeung, R.; Iqbal, J.; et al. PD1 blockade with pembrolizumab is highly effective in relapsed or refractory NK/T-cell lymphoma failing l-asparaginase. Blood 2017, 129, 2437–2442. [Google Scholar] [CrossRef]
- Kim, S.J.; Yoon, D.H.; Kim, J.S.; Kang, H.J.; Lee, H.W.; Eom, H.S.; Hong, J.Y.; Cho, J.; Ko, Y.H.; Huh, J. Efficay of Brentuximab Vedotin in relapsed or refractory high-CD30-expressing non-Hodgkin lymphomas: Results of a multicenter, open-labeled Phase II trial. Cancer Res. Treat. 2020, 52, 374–387. [Google Scholar] [CrossRef] [PubMed]
- Campo, E.; Jaffe, E.S.; Cook, J.R.; Quintanilla-Martinez, L.; Swerdlow, S.H.; Anderson, K.C.; Brousset, P.; Cerroni, L.; de Leval, L.; Dirnhofer, S.; et al. The International Consensus Classification of Mature Lymphoid Neoplasms: A report from the Clinical Advisory Committee. Blood 2022, 140, 1229–1253. [Google Scholar] [CrossRef] [PubMed]
- Feldman, A.L.; Laurent, C.; Narbaitz, M.; Nakamura, S.; Chan, W.C.; de Leval, L.; Gaulard, P. Classification and diagnostic evaluation of nodal T- and NK-cell lymphomas. Virchows Arch. 2022, 1–15. [Google Scholar] [CrossRef] [PubMed]
- Quintanilla-Martinez, L.; Swerdlow, S.H.; Tousseyn, T.; Barrionuevo, C.; Nakamura, S.; Jaffe, E.S. New concepts in EBV-associated B, T, and NK cell lymphoproliferative disorders. Virchows Arch. 2022, 1–18. [Google Scholar] [CrossRef]
- Jeon, Y.K.; Kim, J.-H.; Sung, J.-Y.; Han, J.H.; Ko, Y.-H. Epstein-Barr virus–positive nodal T/NK-cell lymphoma: An analysis of 15 cases with distinct clinicopathological features. Hum. Pathol. 2015, 46, 981–990. [Google Scholar] [CrossRef]
- Kato, S.; Asano, N.; Miyata-Takata, T.; Takata, K.; Elsayed, A.A.; Satou, A.; Takahashi, E.; Kinoshita, T.; Nakamura, S. T-cell receptor (TCR) phenotype of nodal Epstein-Barr virus (EBV)-positive cytotoxic T-cell lymphoma (CTL): A clinicopathologic study of 39 cases. Am. J. Surg. Pathol. 2015, 39, 462–471. [Google Scholar] [CrossRef]
- Takahashi, E.; Asano, N.; Li, C.; Tanaka, T.; Shimada, K.; Shimada, S.; Yoshino, T.; Kojima, M.; Hara, K.; Eimoto, T.; et al. Nodal T/NK-cell lymphoma of nasal type: A clinicopathological study of six cases. Histopathology 2008, 52, 585–596. [Google Scholar] [CrossRef]
- Wai, C.M.M.; Chen, S.; Phyu, T.; Fan, S.; Leong, S.M.; Zheng, W.; Low, L.C.Y.; Choo, S.N.; Lee, C.K.; Chung, T.H.; et al. Immune pathway upregulation and lower genomic instability distinguish EBV-positive nodal T/NK-cell lymphoma from ENKTL and PTCL-NOS. Haematologica 2022, 107, 1864–1879. [Google Scholar] [CrossRef]
- Suzuki, R.; Suzumiya, J.; Nakamura, S.; Aoki, S.; Notoya, A.; Ozaki, S.; Gondo, H.; Hino, N.; Mori, H.; Sugimori, H.; et al. Aggressive natural killer-cell leukemia revisited: Large granular lymphocyte leukemia of cytotoxic NK cells. Leukemia 2004, 18, 763–770. [Google Scholar] [CrossRef]
- Tang, Y.-T.; Wang, D.; Luo, H.; Xiao, M.; Zhou, H.-S.; Liu, D.; Ling, S.-P.; Wang, N.; Hu, X.-L.; Luo, Y.; et al. Aggressive NK-cell leukemia: Clinical subtypes, molecular features, and treatment outcomes. Blood Cancer J. 2017, 7, 660. [Google Scholar] [CrossRef]
- Ishihara, S.; Okada, S.; Wakiguchi, H.; Kurashige, T.; Hirai, K.; Kawa-Ha, K. Clonal lymphoproliferation following chronic active Epstein-Barr virus infection and hypersensitivity to mosquito bites. Am. J. Hematol. 1997, 54, 276–281. [Google Scholar] [CrossRef]
- Ko, Y.H.; Park, S.; Kim, K.; Kim, S.J.; Kim, W.S. Aggressive natural killer cell leukemia: Is Epstein-Barr virus negativity an indicator of a favorable prognosis? Acta Haematol. 2008, 120, 199–206. [Google Scholar] [CrossRef] [PubMed]
- Nicolae, A.; Ganapathi, K.A.; Pham, T.H.; Xi, L.; Torres-Cabala, C.A.; Nanaji, N.M.; Zha, H.D.; Fan, Z.; Irwin, S.; Pittaluga, S.; et al. EBV-negative Aggressive NK-cell Leukemia/Lymphoma: Clinical, Pathologic, and Genetic Features. Am. J. Surg. Pathol. 2017, 41, 67–74. [Google Scholar] [CrossRef] [PubMed]
- Ryder, J.; Wang, X.; Bao, L.; Gross, S.A.; Hua, F.; Irons, R.D.; Ironsa, R. Aggressive Natural Killer Cell Leukemia: Report of a Chinese Series and Review of the Literature. Int. J. Hematol. 2007, 85, 18–25. [Google Scholar] [CrossRef]
- Nakashima, Y.; Tagawa, H.; Suzuki, R.; Karnan, S.; Karube, K.; Ohshima, K.; Muta, K.; Nawata, H.; Morishima, Y.; Nakamura, S.; et al. Genome-wide array-based comparative genomic hybridization of natural killer cell lymphoma/leukemia: Different genomic alteration patterns of aggressive NK-cell leukemia and extranodal Nk/T-cell lymphoma, nasal type. Genes Chromosom. Cancer 2005, 44, 247–255. [Google Scholar] [CrossRef]
- Sumbly, V.; Vest, M.; Landry, I. Aggressive Natural Killer Cell Leukemia: A Brief Overview of Its Genomic Landscape, Histological Features, and Current Management. Cureus 2022, 14, e22537. [Google Scholar] [CrossRef] [PubMed]
- Huang, L.; Liu, D.; Wang, N.; Ling, S.; Tang, Y.; Wu, J.; Hao, L.; Luo, H.; Hu, X.; Sheng, L.; et al. Integrated genomic analysis identifies deregulated JAK/STAT-MYC-biosynthesis axis in aggressive NK-cell leukemia. Cell Res. 2017, 28, 172–186. [Google Scholar] [CrossRef]

| IVNKTL | ENKTL | ANKL | EBV + Nodal T/NK Lymphoma | |
|---|---|---|---|---|
| Median Age and Sex | Adult (middle-age, around 46 yrs) M > F | Adults (elderly, around 60 yrs) M > F | Adult (mainly young adult) M = F | Adult (middle-age, often immunocompromised) M = F |
| Ethnicity | Asian and Latin America | Asian | Asian | Asian |
| Sites | Skin and CNS (mainly); any organ may be involved | Extranodal sites (mainly nasal region and upper aerodigestive tract), very rare primary nodal sites | BM, blood, liver, spleen; very rare nodal presentation | Commonly nodal presentation |
| Nasal involvement | No | Very common | No | No |
| Systemic symptoms | Protean clinical manifestations | B-symptoms | B-symptoms; often CID | B-symptoms |
| Tumor mass | No | Yes, necrotic/ulcerated mass | No | Yes |
| Histology | Large-sized cells within medium- to small-sized vessels | Polymorphic cells, clear cytoplasm; inflammatory background, necrosis. Angioinvasive and angiodestructive pattern. | Variable in size from normal granular lymphocytes to large, atypical cells | High-grade morphology (either polymorphic or monomorphic) |
| Cell of origin | NK or cytotoxic T cells | NK > cytotoxic T cell | NK | Cytotoxic T-cell > NK |
| EBV-association | Common | Common | Common | Common |
| CD56 expression | Often positive | Often positive | Often positive (p16 generally positive) | Often negative |
| T-cell clonality | Present in cases of T-cell origin | Present in cases of T-cell origin | No | Present in cases of T-cell origin |
| Prognosis | Poor | Poor | Poor | Poor |
Publisher’s Note: MDPI stays neutral with regard to jurisdictional claims in published maps and institutional affiliations. |
© 2022 by the authors. Licensee MDPI, Basel, Switzerland. This article is an open access article distributed under the terms and conditions of the Creative Commons Attribution (CC BY) license (https://creativecommons.org/licenses/by/4.0/).
Share and Cite
Zanelli, M.; Parente, P.; Sanguedolce, F.; Zizzo, M.; Palicelli, A.; Bisagni, A.; Carosi, I.; Trombetta, D.; Mastracci, L.; Ricci, L.; et al. Intravascular NK/T-Cell Lymphoma: What We Know about This Diagnostically Challenging, Aggressive Disease. Cancers 2022, 14, 5458. https://doi.org/10.3390/cancers14215458
Zanelli M, Parente P, Sanguedolce F, Zizzo M, Palicelli A, Bisagni A, Carosi I, Trombetta D, Mastracci L, Ricci L, et al. Intravascular NK/T-Cell Lymphoma: What We Know about This Diagnostically Challenging, Aggressive Disease. Cancers. 2022; 14(21):5458. https://doi.org/10.3390/cancers14215458
Chicago/Turabian StyleZanelli, Magda, Paola Parente, Francesca Sanguedolce, Maurizio Zizzo, Andrea Palicelli, Alessandra Bisagni, Illuminato Carosi, Domenico Trombetta, Luca Mastracci, Linda Ricci, and et al. 2022. "Intravascular NK/T-Cell Lymphoma: What We Know about This Diagnostically Challenging, Aggressive Disease" Cancers 14, no. 21: 5458. https://doi.org/10.3390/cancers14215458
APA StyleZanelli, M., Parente, P., Sanguedolce, F., Zizzo, M., Palicelli, A., Bisagni, A., Carosi, I., Trombetta, D., Mastracci, L., Ricci, L., Pancetti, S., Martino, G., Broggi, G., Caltabiano, R., Cavazza, A., & Ascani, S. (2022). Intravascular NK/T-Cell Lymphoma: What We Know about This Diagnostically Challenging, Aggressive Disease. Cancers, 14(21), 5458. https://doi.org/10.3390/cancers14215458










